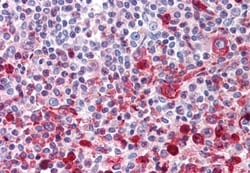
Invitrogen WNT16 Polyclonal Antibody 50 &mu;g | Buy Online | Invitrogen&trade; | Fisher Scientific

missing translation for 'onlineSavingsMsg'
Learn More
Learn More
Invitrogen™ WNT16 Polyclonal Antibody


Beschreibung
Percent identity with other species by BLAST analysis: Human, Gorilla, Gibbon, Monkey (100%) Marmoset, Bovine, Horse (93%) Hamster, Elephant, Pig (87%).
The WNT gene family consists of structurally related genes which encode secreted signaling proteins. These proteins have been implicated in oncogenesis and in several developmental processes, including regulation of cell fate and patterning during embryogenesis. This gene is a member of the WNT gene family. It contains two transcript variants diverging at the 5' termini. These two variants are proposed to be the products of separate promoters and not to be splice variants from a single promoter. They are differentially expressed in normal tissues, one of which (variant 2) is expressed at significant levels only in the pancreas, whereas another one (variant 1) is expressed more ubiquitously with highest levels in adult kidney, placenta, brain, heart, and spleen. WNT15 is also a ligand for members of the frizzled family of seven transmembrane receptors.

Spezifikation
Spezifikation
| Antigen | WNT16 |
| Anwendungen | Immunohistochemistry (Paraffin) |
| Klassifikation | Polyclonal |
| Konzentration | 1 mg/mL |
| Konjugat | Unconjugated |
| Zusammensetzung | PBS with 0.1% sodium azide |
| Gen | Wnt16 |
| Gen-Zugriffsnummer | Q9UBV4 |
| Gen-Alias | E130309I19Rik; Protein Wnt-16; wingless-related MMTV integration site 16; wingless-type MMTV integration site family member 16; wingless-type MMTV integration site family member 16b; wingless-type MMTV integration site family, member 16; Wnt family member 16; Wnt16 |
| Gensymbole | Wnt16 |
| Mehr anzeigen |
Name des Produkts
Indem Sie auf Absenden klicken, erklären Sie sich damit einverstanden, dass Fisher Scientific sich mit Ihnen in Verbindung setzen kann, um Ihr Feedback in diesem Formular zu bearbeiten. Wir werden Ihre Informationen nicht für andere Zwecke weitergeben. Alle bereitgestellten Kontaktinformationen werden in Übereinstimmung mit unserer Datenschutzrichtlinie aufbewahrt. Datenschutzrichtlinie.
Haben Sie Verbesserungsvorschläge?